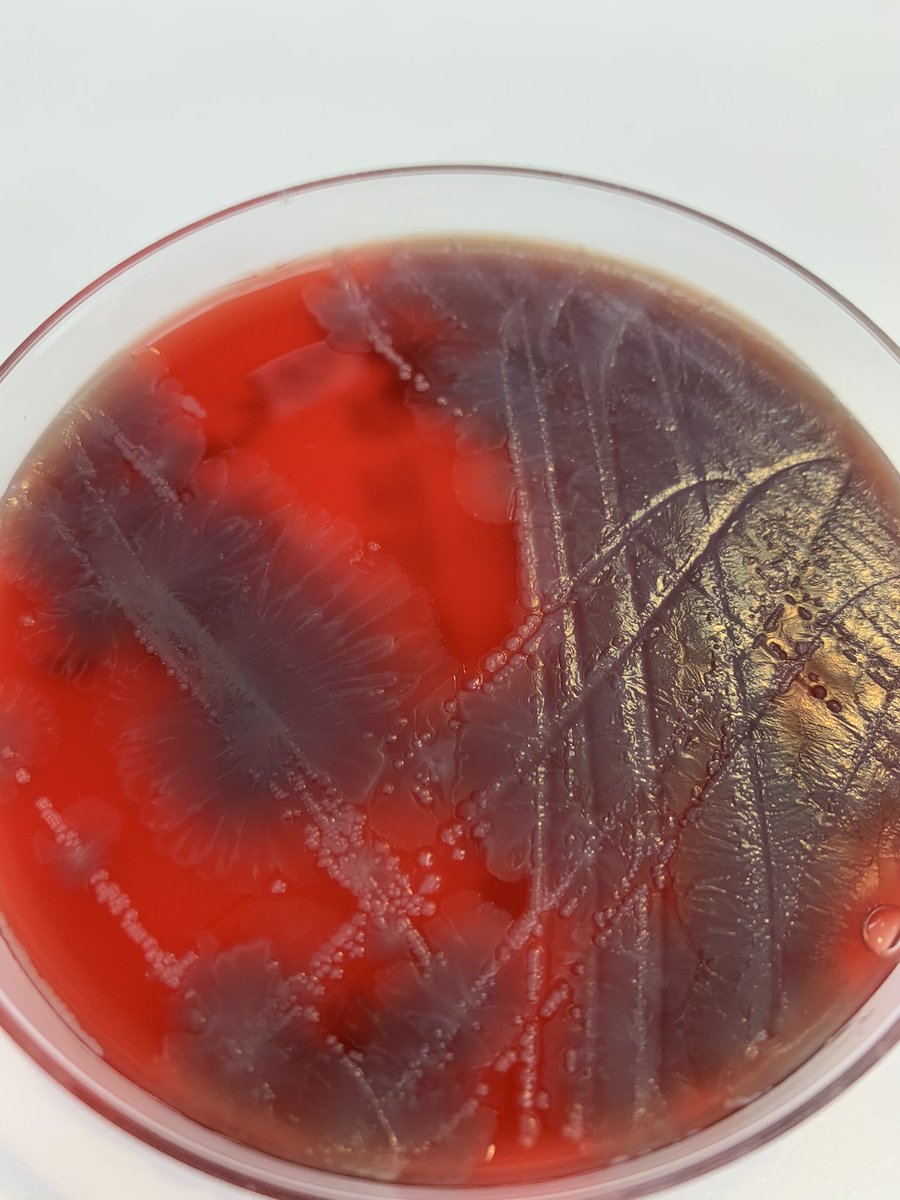
Romney Humphries tweet media

Whitney J Nesbitt
68 posts


For today's grand finale, we drew inspiration from Dikembe Mutombo for some new #antimicrobialstewardship strategies. *We can neither confirm nor deny that antimicrobial stewardship will save you 15% on car insurance.* #USAAW23 #WAAW2023 #WAAW






Good morning and Happy Match Day #TwitteRx! We have unmatched PGY1 Inpatient Positions in Columbia, SC! Please reach out via DM to be connected to our RPD, Laura Holden.

Super excited to unveil the official AdventHealth Orlando Pharmacy Residency hype video! Best part of my job is working with these learners every day! If you’re interested in learning more at a virtual showcase, information is provided below!





Please join us in celebrating @SIDPharm member @whitajones for her outstanding work during the #COVID19 pandemic! Here are a few kind words from her colleagues at @VUMChealth #IDTwitter

